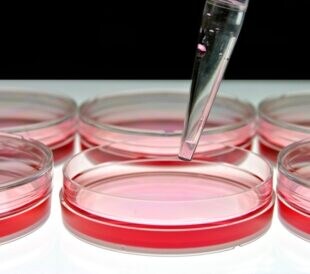

「細胞培養の完全サポートガイド」は、細胞培養に初めて挑戦する方や、まだ経験の浅い方に向けて、基礎知識や準備について解説しています。
前回の「その4」では、細胞の成長と維持に不可欠な培地について紹介しました。その5では、培地に加える血清と抗生物質のポイントについて解説します。

血清とは?
血清とは、血液からフィブリノゲンなどの凝固因子が除かれた液体のことで、細胞培養においてタンパク質、栄養素、接着因子、微量元素、増殖因子、およびホルモンなどの大切な成分を供給します。採血した血液を静置して凝固させると血球と凝固因子が沈殿して血餅となり、その上澄みが血清です。
一方、これまでの説明のとおり、基礎培地とは、一般的には血清成分を含まない培地を指します。しかし、細胞が増えるためには、上述のように血清由来のさまざまな因子が必要です。そのため、多くの場合は基礎培地に5~20%程度の血清を加え、細胞の増殖や維持ができる状態にして、細胞培養で使用します。
なお、ウシ胎仔血清の表記として、Fetal Bovine Serum(FBS)、Fetal Calf Serum(FCS)の2パターンがありますが、両者は同じものです。

では、FBSとはそもそもどういう血清で、なぜ細胞培養にはFBSがよく使われているのでしょうか。
一般的に、細胞培養の血清には主にウシやウマが使われますが、この中で現在もっとも幅広く使用されているのはウシ胎仔血清(FBSまたはFCS)です。
|
ウシ血清の区分け、呼び方一覧 (サーモフィッシャーサイエンティフィック製品の場合): ・ウシ胎仔血清:母体中の胎仔ウシ (Fetal Bovine Serum, FBSまたはFetal Calf Serum, FCS) ・新生仔ウシ血清:生後14日以内の仔ウシ(Newborn Calf Serum, NBCS) ・仔ウシ血清:生後6カ月以内の仔ウシ(Bovine Calf Serum, BCS) ・成ウシ血清:生後12カ月以上のウシ(Bovine Serum, BS) |
この中で、圧倒的にウシ胎仔血清(FBS)が選ばれているのには、理由があります。「なぜウシなのか」「なぜ胎仔血清なのか」の2つに分けて説明しましょう。
・ウシがよく使われている理由:
細胞培養実験でウシの細胞を使う人はまれです。それなのに、なぜウシの血清がよく使われているのでしょうか。
ヒトの培養細胞であればヒトの血清を使うのが本来あるべき姿かもしれません。しかし、全世界で日々行われている細胞培養実験にヒトの血清を使用し続けるのは非常に困難であることは想像に難くありません。一方、ウシは世界中で広く飼育されており、大量生産が可能で、品質管理も行いやすく、何より安定供給が見込めます。細胞培養の歴史の中で、こういった動物の血清でも使用できることがわかったため、ウシの血清が広く利用されています。
もちろん、細胞株によってはウマやウサギなどの特定の血清が推奨されていることもありますので、細胞ごとの推奨血清を必ず確認してください。
・ウシの「胎仔血清」がよく使われている理由:
ウシ胎仔血清とは、生まれる前のウシの血清のことです。
ウシが生まれると、人間と同じように免疫応答系が働き始め、細胞増殖に影響を及ぼすγグロブリンが増えます。一方、ウシ胎仔はこれらが少なく、かつ胎仔の成長を促すために高濃度の増殖因子を含有します。要するに、仔ウシや成ウシ血清よりも、ウシ胎仔血清の方が、細胞を元気に増殖させる成分が豊富で、余計なものが少ないのです。そのため、細胞増殖の促進に理想的とされています。
このように、栄養成分が濃縮された「血清」は細胞培養実験には欠かせないものですが、注意点が2つあります。これらは血清の弱点でもありますので、しっかり把握しておきましょう。
注意点1:ロットのばらつき
血清は、「生体由来」だからこそ、ロットによって培養結果に差が生じやすいという側面があります。再現性の担保が必要な場合は、同じロットの血清をまとめて購入するのがおすすめです。
注意点2:補体の影響と非働化の有無
補体とは、生体が病原体を排除する際、抗体および貪食細胞を補助する免疫に関与するタンパク質のことで、血清中に含まれています。この補体が細胞にダメージを与えることがあるため、培地に混ぜる前に、補体を不活化する処理が行われることがあります。この処理を「非働化」と呼びます。
あらかじめ非働化して販売されている血清もありますし、非働化されていない血清でも、ご自身で、56 ℃で30分、恒温槽内で攪拌しながら処理することで非働化できます。
細胞の入手元の情報には、「heat inactivated」、つまり熱による非働化を経たものが推奨されていることもあります。基本的にはこの指示に従いながら、非働化によって何をどうしているのかを理解しておきましょう。
ただし、非働化によって、大切な栄養素や増殖因子などの活性が落ちてしまうことがあります。そのため、非働化の必要性については、実験目的も考えて慎重に判断する必要があります。また、非働化が必要な場合でも、過度な加熱や長時間の処理は避け、適切な条件で行うことが重要です。
注意点3:血清の保存方法
最後に、血清の保存方法にも注意を払いましょう。Gibco™血清は-10 ℃以下での保存を推奨しており、一般的に、-20 ℃または-80 ℃で保存されます。このときに注意が必要な点は2つあります。まずは、凍結融解を繰り返さないこと。品質が劣化することがあります。1回分ごとに小分けにして保存し、必要なときに解凍することで、品質を維持することができます。2つ目は、ボトルの脆化温度に注意すること。FBSにとっては-80 ℃保存が望ましいですが、製品によってはボトルの脆化温度を下回っていることがあり、ボトルが脆くなっている可能性があります。そのため、衝撃に気を付けてください。また、解凍時は4 ℃に一晩おいて、ボトルが破損しないように確認しながらゆっくりと解凍することをおすすめします。

写真はGibcoTM One Shot FBS(50 mLボトル)
これらのポイントを踏まえ、適切な血清を選び、正しい方法で使用することで、細胞や実験系に最適な条件を整えることができます。
血清の選び方
次に、血清の選び方について解説します。
細胞株を入手する際の推奨培地には、たとえば「Dulbecco’s modified Eagle’s medium with 10% fetal bovine serum」のように、推奨の血清と血清濃度が記載されていることが多いです。基本的にはその情報に従って完全培地を作製してください。
ここで、Gibco血清のラインアップやカタログを見てみましょう。
実は、FBSには複数のグレードがあることが多いです。細胞株の入手元の情報には、血清のグレードまではほぼ指定されていません。ラインアップの中から、どのように目的にかなった血清を選べばよいでしょうか。
ポイント:血清のグレードは実験で求められる品質によって決める
血清のグレードは、ご自身の実験でどこまでの品質が求められるかを元に選択してください。
各グレードでは、品質試験の項目内容や項目数、エンドトキシンレベルなどが異なっています。もちろん品質が高いものを使うに越したことはないのですが、グレードが高くなればなるほど価格も高くなります。
Gibco血清は、Value FBS、Premium FBS、Premium Plus FBSに分かれており、各グレードのコンセプトは以下のとおりです。

それぞれのグレードのコンセプトや、品質チェックの項目などによって、目的の実験で求められるグレードの血清を選びましょう。各血清グレードのプロファイルはこちらです。
抗生物質
抗生物質も、細胞培養前に血清とともに基礎培地へ加えることがあります。
抗生物質とは、細菌の繁殖を抑制する試薬です。私たちが細菌性の風邪をひいたとき、病院で抗生物質を処方されることがあるのと同じように、細胞培養においても、それぞれの抗生物質は特定の細菌、カビ、酵母などの繁殖を抑制する役割を果たします。
ポイント:抗生物質によって有効性が異なる
表1に、細胞培養に使われる主な抗生物質をまとめました。
表1. 細胞培養に使われる主な抗生物質
(コンタミネーション防止に効果があるものに✓)
| サーモフィッシャーサイエンティフィック製品名 | 抗生物質名 | グラム陽性菌 | グラム陰性菌 | 酵母 | カビ | マイコプラズマ | 備考 |
|---|---|---|---|---|---|---|---|
| Gibco™ Antibiotic – Antimycotic | ペニシリン ストレプトマイシン アンフォテリシンB |
✓ | ✓ | ✓ | ✓ | ||
| Gibco™ Penicillin – Streptomycin | ペニシリン ストレプトマイシン |
✓ | ✓ | ||||
| Gibco™ Penicillin-streptomycin GlutaMAX™ Supplement | ペニシリン ストレプトマイシン |
✓ | ✓ | Penicillin streptomycinにGlutaMAX Supplementが加えられたもの | |||
| Gibco™ Penicillin-streptomycin-glutamine | ペニシリン ストレプトマイシン |
✓ | ✓ | Penicillin streptomycinにGibco™ L-Glutamineが加えられたもの |
※研究用にのみ使用できます。診断用には使用いただけません。
こういった表やこちらのサイトの情報などを参考にして、どのようなコンタミネーション(以下コンタミ)を防止したいのかを元に選択してください。
細胞培養実験でよく使用されるのは、細菌の細胞壁合成を防ぐペニシリン、細菌のタンパク質合成を防ぐストレプトマイシンなどで、これらを混合したのがGibco™ Penicillin – Streptomycinです。さらにこれに、カビ・酵母にも使える抗真菌剤入りの抗生物質を加えたGibco™ Antibiotics – Antimycoticsもあります。
抗生物質を使用するときの注意点は2つあります。
注意点1:抗生物質は劣化する
抗生物質は永遠に使用できるものではなく、劣化します。特に液体タイプで冷凍保存製品の場合、凍結融解により性能が低下することがあるため、最初の融解時に小分けしての冷凍がおすすめです。また、冷凍保存が推奨の製品は冷蔵保存により劣化することがあります。製品の推奨保管温度を購入時にしっかり確認してください。
注意点2:抗生物質を入れずに培養するのが、本来は細胞にとってベスト
理由は、抗生物質を使用することによって、細胞に影響を与えないとは限らないためです。
また、細胞培養では、常にコンタミの危険性をはらんでいます。抗生物質が入っている場合、コンタミ発見の遅れにつながってしまうかもしれません。
しかしもちろん、細胞培養に慣れていないうちは抗生物質があった方が安心です。
これらの理由から、かたくなに「入れない」「入れる」と固執することなく、状況に応じて上手に使用することで、トラブルを防ぐことができます。
細胞培養初心者の人は、コンタミを防ぐために、WEBセミナーであらかじめ学んでおきましょう。
参考ブログ:
正体はコレ!細胞培養でのコンタミの原因と対策
まとめ
細胞が元気に増殖し、健康に生きるためには、まだまだ準備は必須です。しっかりと準備を整えてから、細胞たちをお迎えしましょう。次回は接着細胞を剥離する試薬について取り上げます。
シリーズその他の記事はこちら:
参考ブログ&サイト:
GibcoTM 細胞培養ハンドブックダウンロード(フォーム)
研究用または製造用にのみ使用できます。診断目的の使用、ヒトおよび動物への直接的な使用はできません。